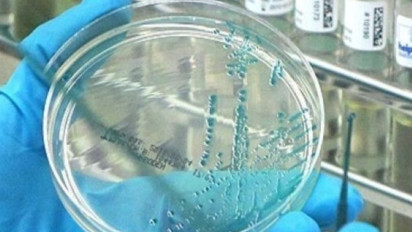
Waspada! Badan Kesehatan Inggris Pastikan Kasus Langka Flu Burung pada Manusia

Waspada! Badan Kesehatan Inggris Pastikan Kasus Langka Flu Burung pada Manusia
- Antara
Jakarta, tvOnenews.com - Sebuah kasus langka infeksi flu burung subtipe A(H5N1) pada manusia telah dilaporkan di Inggris. Hal tersebut menurut Badan Keamanan Kesehatan Inggris (UKHSA).
Pada Desember lalu, Organisasi Kesehatan Dunia (WHO) melaporkan bahwa strain flu burung H5 terdeteksi pada 76 orang sepanjang tahun 2024, dengan 61 di antaranya merupakan petani di Amerika Serikat.
“UKHSA telah mengonfirmasi kasus influenza A(H5N1) pada seseorang di wilayah West Midlands,” demikian pernyataan resmi badan tersebut, mengutip Antara pada Selasa (28/1/2025).
Orang tersebut tertular penyakit itu di sebuah peternakan tempat mereka melakukan kontak erat dengan banyak burung yang terinfeksi dalam waktu yang lama.
Otoritas kesehatan mengatakan pasien telah dirawat di unit khusus dan saat ini dalam kondisi baik. Risiko penyebaran kepada masyarakat luas dinilai sangat rendah.
“Burung-burung tersebut terinfeksi genotipe DI.2, salah satu virus yang diketahui beredar di antara burung di Inggris musim ini. Virus ini berbeda dari strain yang beredar di antara mamalia dan burung di Amerika Serikat,” tambahnya.
Flu burung adalah penyakit infeksi virus akut pada burung yang menyerang sistem pernapasan dan pencernaan, dengan tingkat kematian yang tinggi.
Burung migran, khususnya bebek liar, merupakan pembawa alami virus ini dan lebih tahan terhadapnya dibandingkan burung domestik. Penyakit ini juga dapat menular kepada manusia.(ant/ree)

Load more